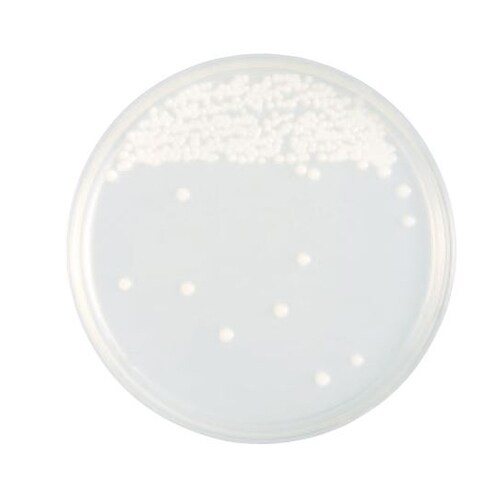
【冷蔵】251359 CG寒天培地 20枚

日本ベクトン・ディッキンソン
BD BBL(TM) サブローデキストロースCG寒天培地 20枚 251359 培地 簡易培地 1個(20枚)
【3167-7417】



| ¥4,932 (税込) / ¥4,484 (税抜) |
| ¥4,932 (税込) / ¥4,484 (税抜) |
| メーカー希望小売価格※税抜 (割引率) ¥4,720(5%) |
|---|
培地関連用品の売れ筋ランキング
- ¥9,927(税込) (税込) 〜
- ¥7,524(税込) (税込) 〜
- ¥11,547(税込) (税込) 〜
- ¥8,162(税込) (税込) 〜
- ¥6,030(税込) (税込)
商品の特徴 |
サブローデキストロースCG寒天培地はサブローデキストロース寒天培地にクロラムフェニコール、ゲンタマイシンを添加することにより、様々な検査材料から病原性あるいは非病原性の真菌を分離するのにおすすめ |
|---|---|
商品仕様 |
|
メーカー情報 |
|
カタログ掲載ページ |
-/- |
| 注意事項 | ※この商品は貯蔵または配送の際に冷蔵が必要な商品です。 |
|---|